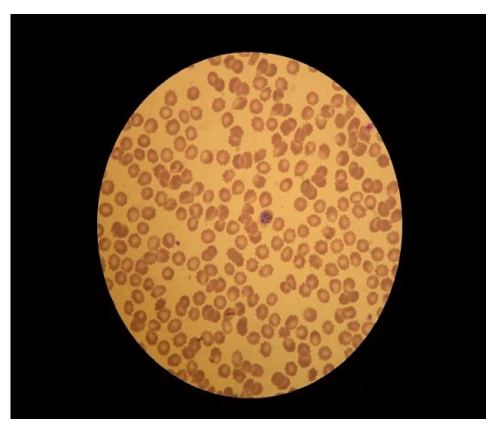

A 71 year old Caucasian lady attended A & Every unwell with headache, diarrhoea and vomiting. The only finding on examination was nonspecific abdominal tenderness...
Continue readingVolume 1 Issue 5 - 2020
Risk Factors for Malignant Melanoma in Romania

In all ages of population in the recent decades, Malignant melanoma is the most dangerous type of skin cancer in the whole world. Its incidence has increased worldwide and that for and earlier diagnosis programs, who reduce the morbidity and mortality of the malignant disease...
Continue readingRole of Dietary Factors in Prevention and Control of Thyroid Disorders: A Primary Care Perspective
Thyroid disorders are one of the most common endocrine problems encountered at primary care. Role of dietary factors in their prevention and management are largely unknown with inadequate scientific evidences. In this review, we examine the scientific evidences on the role of various dietary elements in causation, prevention, and management of thyroid disorders.
Continue readingImportance of pin-vise of duct occluder during percutaneous closure of Patent Ductus Arteriosus (PDA)

Patent ductus arteriosus (PDA), a persistent left to right shunt at great arterial level, accounts up to 10% of all congenital heart disease. Here, we report a case of a 6-month old baby with large PDA (5mm) whose percutaneous closure was planned...
Continue reading